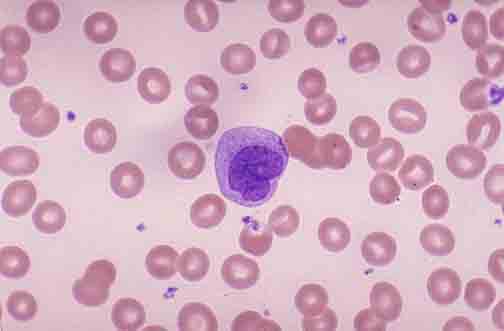
单核细胞(m,mono)

成熟单核细胞

单核细胞 细胞较大,直径14~20um,呈圆形或卵圆形.
图片尺寸974x1280
单核细胞 细胞较大,直径14~20um,呈圆形或卵圆形.
图片尺寸1007x1280
单核细胞
图片尺寸2448x3264
图19 成熟单核细胞
图片尺寸1115x863
淋巴细胞末图为单核细胞#显微镜下的世界 #细胞 - 抖音
图片尺寸1440x2560
单核细胞血细胞形态学检查
图片尺寸524x699
单核细胞空泡现象及粒细胞毒性变化 感谢徐老师解答疑惑#显微镜 - 抖
图片尺寸1440x2560
医学检验形态学7915单核细胞56615
图片尺寸788x1051
医学检验形态学7915单核细胞56615 单核细胞 monocytes 约占
图片尺寸788x1051
单核细胞
图片尺寸1088x1080
单核细胞
图片尺寸1200x900
成熟单核细胞偏高,意味着什么健康信号?
图片尺寸1242x1660
9999 单核细胞系统包括原始单核细胞,幼稚单核细胞,成熟单核细胞
图片尺寸1280x1706
医学检验形态学7915单核细胞56615
图片尺寸788x1051
5%,其中原始,幼稚单核细胞占55.
图片尺寸1920x2560
单核与淋巴细胞鉴别篇78787878 单核细胞与淋巴细胞鉴别篇
图片尺寸1080x1437
单核细胞(m,mono)
图片尺寸504x331
5%,其中原始,幼稚单核细胞占55.
图片尺寸1920x2560
5%,其中原始,幼稚单核细胞占55.
图片尺寸1920x2560
单核细胞计数
图片尺寸3200x1800